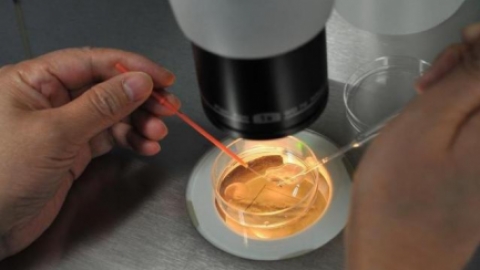

什么是宫颈糜烂,什么症状是宫颈糜烂预兆?
在我们的日常生活中,宫颈糜烂是一种更常见的妇科疾病,有很多女性朋友被宫颈糜烂困扰,你知道什么是宫颈糜烂,宫颈糜烂的症状是什么。宫颈糜烂是一种由激素引起的正常生理现象。因此,很多女性在流产后会发现自己患...
08-22

超过40岁的高龄女性,为好孕再战泰国试管婴儿能否如愿?
年龄不仅影响自然受孕的概率,也影响泰国试管婴儿的成功率。很多去泰国做试管婴儿的女性朋友大多30岁以上。因此,泰国试管婴儿是老年人最好的生育方式。虽然说了这么多,但年龄对女性的生育能力影响很大,无论是自...
08-22

人工授精和试管婴儿有什么不同?医生一般不会告诉你
鉴于这种情况,人工授精和试管受精是常见的辅助生殖手段,那么两者有什么区别呢?与其他辅助生殖技术相比,人工授精由于损伤小、成本低,往往优先。体外受精与人工授精最大的区别在于体外受精,即体外受精-胚胎移植...
08-22
听说试管婴儿能选性别?真的吗?试管婴儿误区有哪些?
很多人想去泰国做试管婴儿是因为听说泰国那边的试管婴儿技术可以选性别?那么是不是真的呢?常见的对试管婴儿的误区又有哪些?试管婴儿技术:
09-28

试管促排后,医生会安排时间去打夜针,什么是夜针呢?
做过试管婴儿的都知道,在试管促排玩之后,医生会安排时间打夜针,夜针是什么?为什么要打夜针呢?关于打夜针的相关问题,喜点小编在这里就
09-27

促排前期饮食方面有何要求?
进行泰国试管婴儿之时前期身体检查没什么情况的话接下来就是打促排针,促排卵也是泰国试管婴儿流程的重要环节之一,也是泰国试管能否成功的关键,因此,在做泰国试管促排前食物应该做些准备,准备些什么呢?让喜点小...
09-17

高龄做泰国试管婴儿如何提高试管着床率呢/
由于控制性超排卵在低反应的高龄妇女中的效能低下,而自然周期避免此缺陷,自然周期IVF在低反应人群可获得与COH相同的结局,因而是卵巢反应不良的一种有效的治疗手段。
09-17

感染了HPV病毒可以做试管婴儿吗?
09-14

梗阻性无精症造成不育可以做泰国第三代试管婴儿吗?
09-10


孕早期做阴超会影响胚胎发育吗?
有人说孕早期不能做阴超,因为会影响胚胎的发育,甚至有人因此早产,是不是真的呢?其实这是对阴道B超的一种误解,B超是一种利用超声波进行非侵入性检查的临床检查技术,妇科B超检查包
09-01

